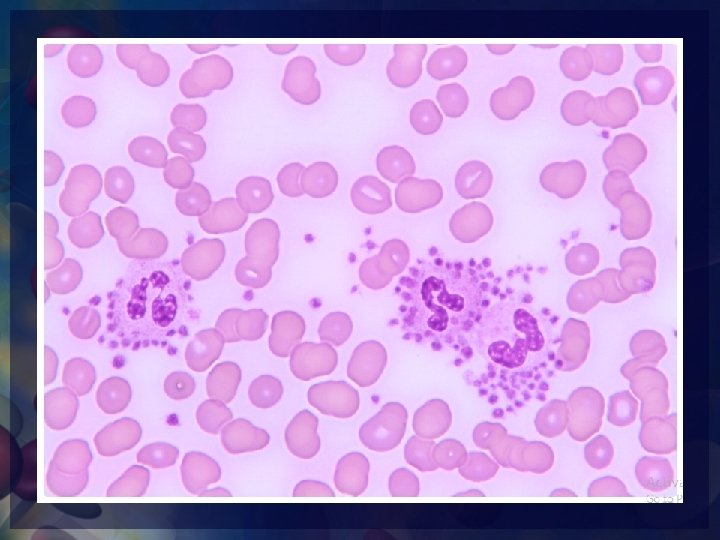
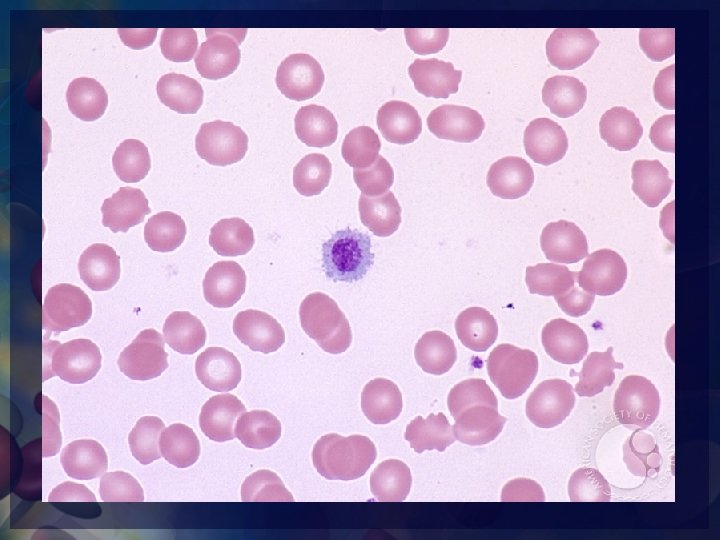
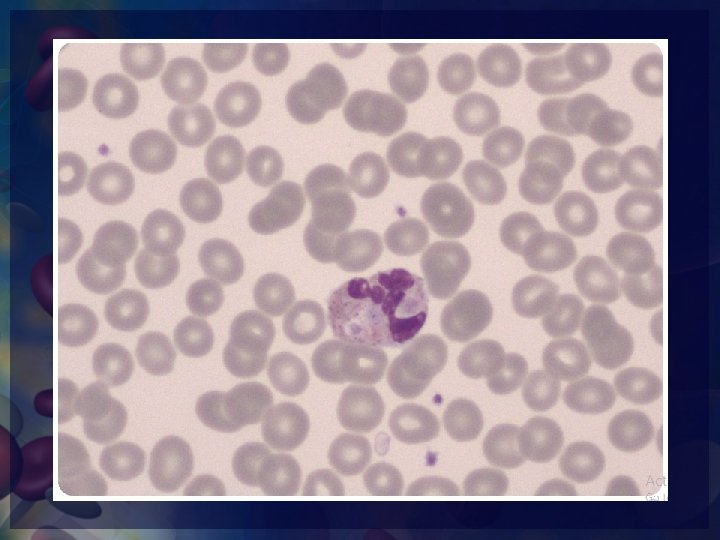

Practical Hematology Lab LAB WBCs PLT Abnormal Morphology

Practical Hematology Lab - LAB - WBCs & PLT Abnormal Morphology

Platelet Satellitism Morphology Platelets clumped around neutrophils. Found in EDTA in vitro induced change of no clinical significance except false low platelet count (in vitro).

Giant Platelets Morphology Platelet larger than a normal red cell. Found in § Increased platelet turnover § Myeloproliferative disorders § Myelodysplastic disorders

Large Platelets Morphology Large platelets - larger than one third but less than the size of a red cell. Found in § Increased turnover of platelets § Myeloproliferative disorders § Myelodysplastic disorders § May Hegglin anomaly § Grey platelet syndrome § Bernard Soulier

Micro Clots Morphology Fibrin strands, platelets and white cells (in this case - neutrophils) clumped together. Found in In vitro artifact caused by poor venesection technique leads to false low counts - can influence white cell, red cell and platelet counts

Platelet Clumping Morphology Small clumps of platelets. Found in § In vitro artifact caused by EDTA or cold and leads to false low platelet count. § Difficult venesection

Small plateletes Morphology Small platelets. Found in § Wiskott Aldrich syndrome

Degranulation of Plateletes Morphology Platelets appear degranulated. Found in § Grey platelet syndrome § Discharge of platelet granules in vivo (cardiopulmonary bypass, hairy cell leukemia) § Discharge of platelet granules in vitro (poor venesection technique)

Abnormal WBCs

Drumstick Morphology Drumstick shaped nuclear appendage. ± 1, 5 µm in diameter and attached to the nucleus by a filament. Inactive X chromosome of the female. Found in § Neutrophils of females § Males with Klinefelter syndrome

Sessile Nodule Morphology Inactive X chromosome found as nodule on neutrophils of females. Found in § Neutrophils of females

• Different forms of appendages (arrow): A) form A (drumstick), B) form B (sessile nodules), C) and D) form C (C: tag and D: hook).

Hypersegmentation or right shift of neutrophil nuclei Morphology Average lobe count increased OR increased % of neutrophils with 5 - 6 lobes OR > 3% neutrophils with 5 lobes or more. Found in § Megaloblastic anaemia § Iron deficiency § Chronic infection § Liver disease § Uraemia

Hypersegmentation

Ring shaped nuclei Morphology Nucleus ring or doughnut shaped. Found in § Acute myeloid leukemia § Chronic granulocytic leukaemia § Megaloblastic anaemia § MDS

Detached Nuclear Fragments Morphology Detached nuclear material in cytoplasm. Found in § Dysgranulopoiesis § Patients on anti cancer chemotherapy § HIV

Toxic Granulation Morphology Increased granulation. Granulation more basophilic and larger than normal. Found in § Severe bacterial infection. § Non specific finding - seen in tissue damage of various types. § Normal pregnancy. § Therapy with cytokines

Toxic Granulation

Hypogranulation Morphology Reduced granulation in neutrophil cytoplasm. Found in § Myelodysplastic syndromes

Dohle Bodies Morphology Small pale blue cytoplasmic inclusions, often in the periphery of the cell. Consist of ribosomes and endoplasmic reticulum Found in § Infective and inflammatory states. § Severe burns § Tuberculosis § Post chemotherapy § Pregnancy § May-Heggling Anomaly

Russell bodies Morphology Are eosinophilic, large, homogenous immunoglobulin-containing inclusions Found in a plasma cell undergoing excessive synthesis of immunoglobulin; the Russell body is characteristic of the distended endoplasmic reticulum This is one cell variation found in chronic inflammation and malignant disorders e. g. multiple myeloma.

Phagocytosed Parasites Morphology Malaria - Plasmodium falciparum Found in § Severe malaria infection

Phagocytosed Platelet Morphology Platelet in vacuole in neutrophil cytoplasm Found in § Infection

Phagocytosed Red blood cell Morphology Red cell in vacuole in cytoplasm of neutrophil Found in § Infection § Auto immune haemolytic anaemia § Incompatible blood transfusion

Vaculization

Auer Rods Morphology Small azurophil rods in the cytoplasm of myeloblasts and promyelocytes. Sometimes found in mature neutrophils. Found in § Acute myeloblastic leukemia. § Myelodysplastic syndromes.

Auer Bodies(auer Rod)

Macro Neutrophils Morphology Twice the size of a normal neutrophil with tetraploid DNA content. Found in § Occasionally in the blood of healthy subjects. § Inherited § Administration of G-CSF § Megaloblastic anaemia § Chronic infection

Necrobiotic / Apoptotic neutrophil Morphology Dense homogenous nuclei (pyknotic) Found in § Occasionally in healthy subjects In vitro artifact. § AML

Shift To The Left Morphology Presence of precursor of granulocytes in the peripheral blood Found in § Normal in pregnancy or neonate. § Infections. § Bone marrow fibrosis. § Bone marrow infiltration by malignancies.

Pseudo Pelger Huet Anomaly Morphology Bilobed neutrophils with more condensed chromatin Found in § Inherited Myelodysplastic syndromes. § Idiopathic myelofibrosis. § Chronic granulocytic leukemia. § Therapy with colchicine, ibuprofen. § Infectious mononucleosis, malaria, myxedema. § CLL

Neutrophil aggregation Morphology Small clumps of neutrophils. Happens in vitro if EDTA anticoagulated blood is allowed to stand. May lead to incorrect WBC. Found in § In vitro finding. § Infectious mononucleosis. § Bacterial infections. § Auto immune disease.

Atypical Lymphocytes Morphology Pleomorphic. Large with diameter of 15 - 30 µm. Abundant, strongly basophilic cytoplasm. Basophilia may be confined to the cytoplasmic margins. Found in § § § Viral infections - EBV, CMV, Hep A, Measles. Bacterial infections - brucella, tuberculosis. Protozoa – malaria. Immunization. SLE.

Plasmacytoid Lymphocyte Morphology Lymphocyte with basophilic cytoplasm and eccentric nucleus. Found in § Reactive phenomenon

Mott cell Morphology Plasmacytoid lymphocyte with globular inclusions composed of immunoglobulin. Found in § Reactive changes in peripheral blood.

Large Granular Lymphocyte Morphology Small eosinophilic granules in the cytoplasm of large lymphocytes. Found in § Natural killer cells. § Lymphokine activated T cells.

Monocyte Vacuolization Morphology Vacuoles in the cytoplasm of monocytes. Found in § Infections

Chediak-Steinbrink-Higashi Anomaly Chediak-Higashi syndrome (CHS) is a rare autosomal recessive disorder characterized by recurrent pyogenic infections, partial oculocutaneous albinism, progressive neurologic abnormalities, mild coagulation defects.

Dohle Body

Anisocytosis Of Neutrophils

Degeneration Of Nucleus

- Slides: 45